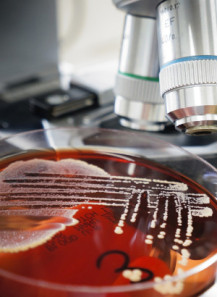
Microbial Challenge Test

Stability Testing

Stability Testing Service for cosmetics and food formulation
Cart
No products
Subtotal:
0.00
Total
0.00
THB